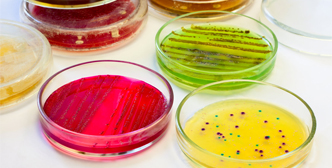
Application of Incubator Shaker in Microbiology and Cell Culture

DESCRIPTION
OH series flask shaker is suitable for centralized constant temperature and cluster oscillation in a specific constant temperature room. Not only can it provide a high level of oscillation efficiency for mass production operations and biopharmaceutical research applications in pilot trials and mass strain screening, but also has strong economic and practicality.LH-311TD/322TD is an extra large amplitude type with an amplitude of 100mm.LH-300D/311D/322D is a single-layer type with an amplitude of 50mm.LH-3112/3222/3332/3432 is a double-layer large-capacity type with an amplitude of 50mm.LH-331/332/3312 is a reciprocating oscillation type .
FEATURES
1. Eight sections of self-programming, each program can set different speed and time to realize the programming operation of speed and appointment time.
2. Automatic operation, automatic stop, timed operation, clock display, call recovery, parameter memory.
3. Watchdog timers, independent overspeed sound/light alarms, independent leakage, and over-current protection devices do not affect other equipment.
4. The PID microprocessor control/monitoring system provides simple button operation and easy programming of time and speed.
5. The original single-axis drive mechanism in China is quiet and durable.
6. The most advanced finishing technology in the country ensures the stability and reliability of mechanical operation.
7. The key parts of the movement are made of expensive chrome alloy material, high quality cast iron and original imported bearings.
8. The last set speed is automatically memorized and slowly accelerated to the last running speed after power on.
9. The unique slow start line prevents sudden starts and splashes, ensuring safe reagents.
10. Unique motor overheating, temperature out of control automatic power off protection device.
11. Unique high-precision frequency control system with frequency accuracy of ±1rpm.
12. The most advanced large torque motor, maintenance-free, and guaranteed continuous operation.
13. The electrostatic color spray box is beautiful and rustproof, and has an aesthetic design concept.
14. The cabinet is made of high quality, high strength cold rolled steel, medium, channel, angle and cast iron.
Security
1. Leakage current and overcurrent protection systems ensure operator safety.
2. Ultra-temperature, over-speed sound and light alarm emergency control system to ensure sample safety.
SPECIFICATIONS
| Model | OH-331 | OH-332 | OH-3312 |
| Control method | PID microcomputer environment scanning micro-processing chip control | ||
| Display method | LCD liquid crystal display | ||
| Programming control | Eight-segment user-programming | ||
| Safety protection | Automatic operation, automatic stop, timed operation, clock display, call recovery, parameter memory | ||
| Accessory function | Watchdog timer, independent overspeed sound/light alarm, independent leakage, leakage overcurrent protection device | ||
| Cyclic mode | Natural convection | ||
| Oscillation mode | Reciprocating oscillation | ||
| Drive mode | Track balanced drive | ||
| Environmental requirements | User-specific thermostat or environment | ||
| Rotation frequency | 30-300rpm | ||
| Timing range | 0-999.59 hours / sustainable | ||
| Rotation accuracy | ±1rpm | ||
| Pendulum amplitude | Φ25mm | ||
| Rocker size | 840*620(mm) | 1108*740(mm) | 840*620(mm) |
| Number of rocking plates | one | one | two |
| Net weight | 200kg | 250kg | 250kg |
| Dimensions | 900*650*480 (mm) | 1210*795*480 (mm) | 910*680*850(mm) |
| Outer box material | High quality and high strength cast iron, channel steel, angle steel, cold rolled steel | ||
| Power supply | AC 200-240V 50-60HZ | ||
| Motor | 120W Inverter motor) | 250W Inverter motor | 250W Inverter motor |
| Power | 150W | 280W | 280W |
APPLICATION
Microbiology and Cell Culture
Biochemical and Enzyme Research
Chemical and Pharmaceutical Research
Molecular Biology and Genetics
WHY CHOOSE US
- Factory direct sales with competitive price.
- Premium quality with CE & ISO certification.
- Strong product OEM & ODM customization capability.
- Promise production & on-time delivery.
- Perfect after-sales service, free product accessories.
- 15 years of experience in R&D and production of centrifugal extractor machine.

OUR FACTORY
We have a standard production workshop and a complete production team. They always produce a serious and responsible attitude to produce each product. Our R&D team is made up of multi-aspects professional engineers such as design engineer,technology specialist ,qualified specialist and process control manager, etc. Our qualified specialists strictly realize the process comprehensive supervision based on our quality process control system, which contains products design, research and development, test, production, quality inspection and packaging.

PACKAGING & SHIPPING
Our product packaging has been proven over the long term and we usually have plywood boxes or cartons with trays. We will arrange the appropriate packaging according to the weight and size of the goods. Of course, you can also choose the packaging form.
CUSTOMER CASES
Our laboratory instruments and equipment are used in many scientific laboratories, scientific research institutions, universities, hospitals, centers for disease control and other institutions, and are combined with many well-known biopharmaceuticals, new energy, electronics companies, food processing, environmental protection, etc. Enterprise cooperation, our stable and reliable products are exported to more than 120 countries around the world, and have been highly recognized by them, believe OQTSUPPLIES, we grow together!